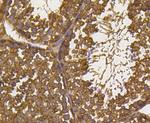
Ubiquitin Antibody in Immunohistochemistry (Paraffin) (IHC (P))

Search
Invitrogen
Ubiquitin Recombinant Rabbit Monoclonal Antibody (ST46-03)
{{$productOrderCtrl.translations['antibody.pdp.commerceCard.promotion.promotions']}}
{{$productOrderCtrl.translations['antibody.pdp.commerceCard.promotion.viewpromo']}}
{{$productOrderCtrl.translations['antibody.pdp.commerceCard.promotion.promocode']}}: {{promo.promoCode}} {{promo.promoTitle}} {{promo.promoDescription}}. {{$productOrderCtrl.translations['antibody.pdp.commerceCard.promotion.learnmore']}}
图: 1 / 7
Ubiquitin Antibody (MA5-41131) in ICC/IF

Please note: We are reviewing Western blot images included in the antibody testing data in our catalog, including those provided by third parties. Unless expressly labeled or annotated as “raw-unedited”, Western blot images included in the antibody testing data in our catalog may have been edited, optimized or otherwise adjusted for presentation.
产品信息
MA5-41131
种属反应
宿主/亚型
Expression System
分类
类型
克隆号
抗原
偶联物
形式
浓度
规格
纯化类型
保存液
内含物
保存条件
运输条件
RRID
产品详细信息
This product is predicted to work in Western Blot at a dilution of 1:1,000-1:2,000.
靶标信息
Ubiquitin, a highly conserved protein that has a major role in targeting cellular proteins for degradation by the 26S proteosome, is synthesized as a precursor protein consisting of either polyubiquitin chains or a single ubiquitin fused to an unrelated protein. This gene encodes a fusion protein consisting of ubiquitin at the N terminus and ribosomal protein S27a at the C terminus. When expressed in yeast, the protein is post-translationally processed, generating free ubiquitin monomer and ribosomal protein S27a. Ribosomal protein S27a is a component of the 40S subunit of the ribosome and belongs to the S27AE family of ribosomal proteins. It contains C4-type zinc finger domains and is located in the cytoplasm. Pseudogenes derived from this gene are present in the genome. As with ribosomal protein S27a, ribosomal protein L40 is also synthesized as a fusion protein with ubiquitin; similarly, ribosomal protein S30 is synthesized as a fusion protein with the ubiquitin-like protein fubi. Multiple alternatively spliced transcript variants that encode the same proteins have been identified.
仅用于科研。不用于诊断过程。未经明确授权不得转售。
篇参考文献 (0)
生物信息学
蛋白别名: 40S ribosomal protein S27-like; 40S ribosomal protein S27-like protein; 60S ribosomal protein L40; CEP52; Chap1; hPLIC-2; HRIHFB2157; HUBCEP52; OTTHUMP00000200786; OTTHUMP00000201692; PLIC-2; polyubiquitin C; Polyubiquitin-B; Polyubiquitin-C; Ribosomal protein eS27-like; ribosomal protein S27; RPL40; RPS27A; rps27l; Small ribosomal subunit protein eS27-like; UBA52; UBB; UBC; Ubiquilin 2; Ubiquitin A-52 residue ribosomal protein fusion product 1; ubiquitin C; Ubiquitin carboxyl extension protein 80; ubiquitin-40S ribosomal protein S27a; ubiquitin-40S ribosomal protein S27a-like; ubiquitin-60S ribosomal protein L40; Ubiquitin-ribosomal protein eL40 fusion protein; Ubiquitin-ribosomal protein eS31 fusion protein; ubiquitin/60S ribosomal fusion protein
基因别名: 0610006J14Rik; 1810034D23Rik; 2700054O04Rik; AI194771; AL033289; D8Ertd21e; Gm1863; RPS27A; RPS27L; TI-225; UBA52; UBA80; UBB; Ubb2; UBC; UBCEP1; UBCEP2
UniProt ID: (Rat) P62982, (Mouse) P62983, (Rat) P24051, (Mouse) Q6ZWY3, (Mouse) P62984, (Rat) P62986, (Mouse) P0CG49, (Rat) P0CG51, (Mouse) P0CG50, (Rat) Q63429
Entrez Gene ID: (Rat) 100912032, (Mouse) 78294, (Rat) 681429, (Mouse) 67941, (Mouse) 22186, (Rat) 64156, (Mouse) 22187, (Rat) 192255, (Mouse) 22190, (Rat) 50522




